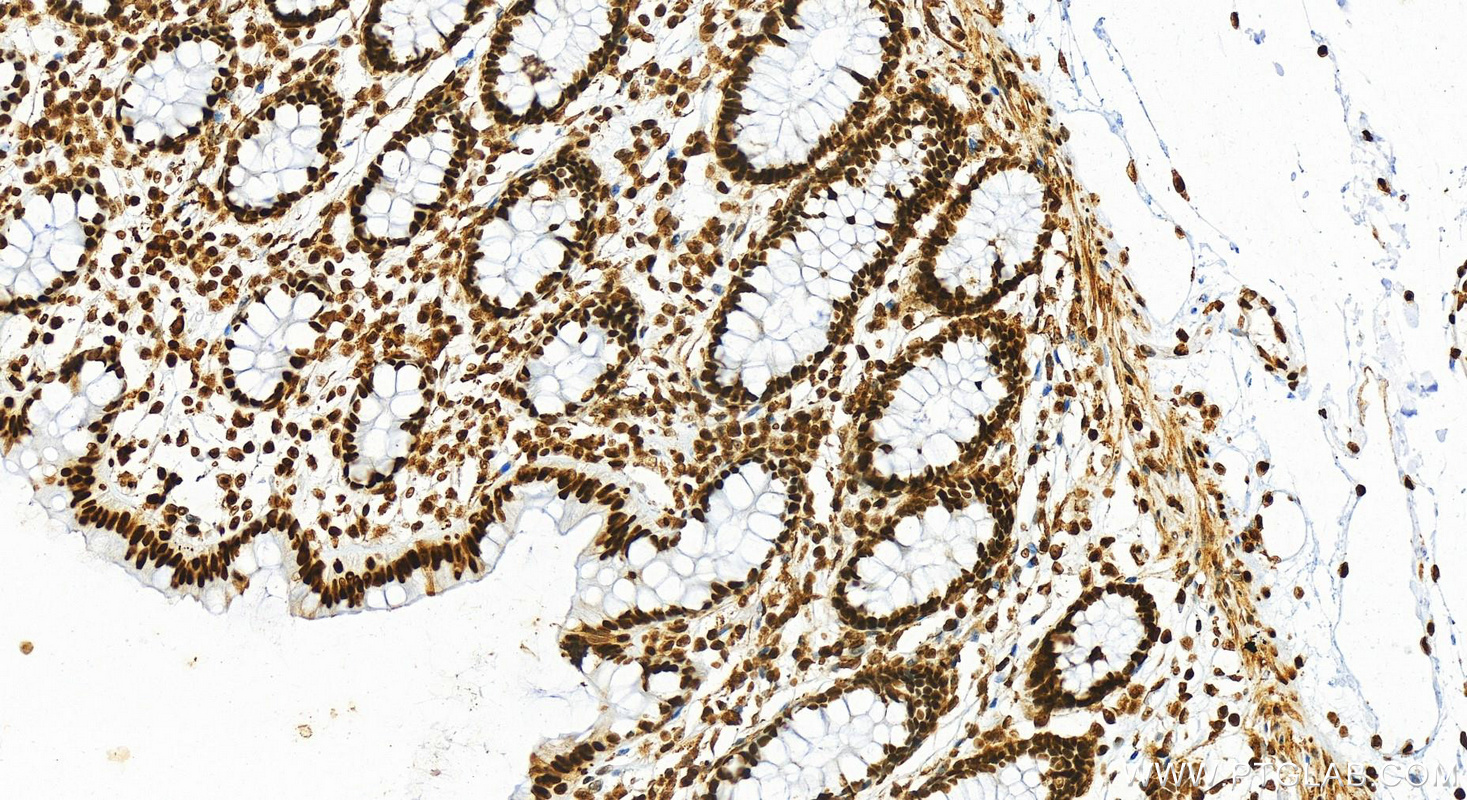

验证数据展示
产品信息
82973-1-PBS targets HMGB1 in WB, IHC, IF/ICC, FC (Intra), Sandwich ELISA, Indirect ELISA applications and shows reactivity with human, mouse, rat samples.
| 经测试应用 | WB, IHC, IF/ICC, FC (Intra), Sandwich ELISA, Indirect ELISA Application Description |
| 经测试反应性 | human, mouse, rat |
| 免疫原 |
CatNo: Ag1264 Product name: Recombinant human HMGB1 protein Source: e coli.-derived, PGEX-4T Tag: GST Domain: 1-215 aa of BC003378 Sequence: MGKGDPKKPRGKMSSYAFFVQTCREEHKKKHPDASVNFSEFSKKCSERWKTMSAKEKGKFEDMAKADKARYEREMKTYIPPKGETKKKFKDPNAPKRPPSAFFLFCSEYRPKIKGEHPGLSIGDVAKKLGEMWNNTAADDKQPYEKKAAKLKEKYEKDIAAYRAKGKPDAAKKGVVKAEKSKKKKEEEEDEEDEEDEEEEEDEEDEDEEEDDDDE 种属同源性预测 |
| 宿主/亚型 | Rabbit / IgG |
| 抗体类别 | Recombinant |
| 产品类型 | Antibody |
| 全称 | high-mobility group box 1 |
| 别名 | 230182G6, high mobility group box 1, High mobility group protein 1, High mobility group protein B1, HMG 1 |
| 计算分子量 | 25 kDa |
| 观测分子量 | 25-30 kDa |
| GenBank蛋白编号 | BC003378 |
| 基因名称 | HMGB1 |
| Gene ID (NCBI) | 3146 |
| 偶联类型 | Unconjugated |
| 形式 | Liquid |
| 纯化方式 | Protein A purification |
| UNIPROT ID | P09429 |
| 储存缓冲液 | PBS only, pH 7.3. |
| 储存条件 | Store at -80°C. The product is shipped with ice packs. Upon receipt, store it immediately at -80°C |
背景介绍
The HMG (high mobility group) proteins are nonhistone chromosomal proteins that is present in almost all eukaryotic cells, and it functions to stabilize NUCLEOSOME formation and acts as a transcription-factor-like protein that regulates the expression of several genes[PMID: 18160415]. Once injury, infection or other inflammatory stimuli, activated macrophages, mature dendritic cells and natural killer cells can secret HMGB1, which act as a crucial cytokine[PMID: 20163887]. HMGB1 also involved in V(D)J recombination by acting as a cofactor of the RAG complex, stimulating cleavage and RAG protein binding at the 23 bp spacer of conserved recombination signal sequences (RSS)[PMID: 19360789 ]. Act as a Heparin-binding protein that has a role in the extension of neurite-type cytoplasmic processes in developing cells. HMGB1 (high mobility group box 1) modulates gene expression in the nucleus, but certain immune cells secrete HMGB1 as an extracellular Alarmin to signal tissue damage.The nuclear HMGB1 relocalizes to the extracellular milieu in senescent human and mouse cells in culture and in vivo, which stimulated cytokine secretion through TLR-4 signaling (23649808).